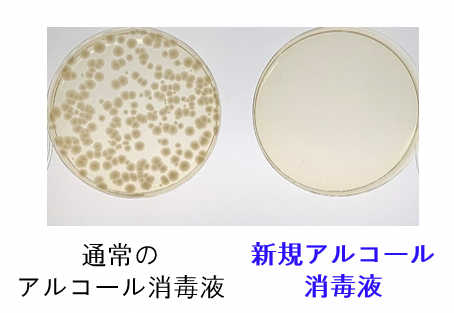

ここから本文です。
知恵の経営、元気印、経営革新、チャレンジ・バイの各認定等を受けた府内中小企業を紹介するページです。
(令和6年1月19日追記)
(令和6年1月9日 ものづくり振興課 白石)
ジヨイ・クル株式会社(外部リンク)(京田辺市)代表取締役社長で、京都府立大学准教授の宮崎孔志さんにお話をうかがいました。
―まずは、御社の事業概要を教えてください。
宮崎)皮膚常在菌に着目した、肌トラブルを解決する技術の研究開発をしているスタートアップ企業です。私自身は京都府立大学で病原細菌学・皮膚科学を専門に研究しており、その中で皮膚常在菌の重要性を認識したことをきっかけに、肌トラブルに悩まない世の中にしたいと思い起業しました。
―そもそも、皮膚常在菌とは、、、?
宮崎)肌に生息し、肌環境を守っている多くの細菌のことです。一般的には菌と聞くと殺菌した方が良いと思われがちですが、皮膚常在菌には病原菌やアレルギー物質の侵入を防いだり、肌から水分が蒸散するのを抑える機能がある事が分かっています。
しかしながら、化粧品やシャンプーに使われている防腐剤によって皮膚常在菌は死滅してしまうのです。現在世の中に出回っている製品で防腐剤が一切添加されていないものはなく、60%以上の人が肌トラブルに悩んでいる、と言われています。
―では、どのようにして皮膚常在菌を守ればよいのでしょうか?
宮崎)そこで、防腐剤無添加でも製品が腐敗しない新技術を開発しました。この技術を活用し、防腐効果のある物質をプラスチック容器にコーティングしたり、容器に練り込むことで、中身の腐敗を防ぎます。容器が腐敗を防止する事が出来れば製品に防腐剤を添加する必要が無くなるため、皮膚常在菌を守れる製品の開発が可能になります。


―ちなみに、「抗菌まな板」などのプラスチックとは異なるのでしょうか?
宮崎)これまで、多くの抗菌プラスチックが開発されていますが、その大きな欠点として、抗菌プラスチックに接触した面でないと抗菌性が発揮できないという点があります。これでは、化粧品やシャンプーの容器としては、接触しない面で雑菌が繁殖してしまいます。
そこで、接触しない面でも抗菌性を発揮する新しいプラスチックを開発しました。これは、微生物の増殖に必要なある栄養成分を除去できる物質をプラスチックに配合することで達成しました。
右図が従来の抗菌プラスチックとの比較を示したものです。いずれも、培養ビンの底にプラスチックを作った上に培地を注ぎ、緑膿菌(低栄養でも増殖する厄介な細菌)を培養した結果です。左2本は従来の抗菌プラスチックでの結果ですが、振盪培養(常に撹拌し細菌が抗菌プラスチックに接触する)では抗菌性が発揮されますが、静置培養(撹拌せず細菌が接触しない)だと抗菌性が発揮されません。しかし、開発した物質(物質X)を配合したプラスチックでは、静置培養でも抗菌性が発揮されました。
この結果、各種液体製品に防腐剤を配合せずとも製品が腐敗しない新しいプラスチック容器が開発されたことになります。緑膿菌以外の細菌2種およびカビ2種でも効果を確認しています。
―容器で腐らないようにできれば、中身に防腐剤を入れなくて済む、ということですね。
宮崎)はい。また、病原菌による毒素の産生を抑える技術も開発しました。現在は病原菌を殺菌することで皮膚の炎症を抑えるのが主流ですが、これでは皮膚常在菌も死滅してしまいます。
そこで、感染の原因となる病原菌を無菌化することで、炎症を抑える技術を開発しました。この技術を用いた軟膏を試した方から、「すぐに傷が治った」「アトピーが良くなった」などの感想の他に、「痒みもなくなった」との声もいただきました。痒みが抑えられることは想定していなかったので、これは私にとっても驚く結果でした。
―病原菌を無菌化すれば、治りが早くなるということでしょうか?
宮崎)というよりも、病原菌を無菌化する、つまり悪い菌がいなくなることで、人間の自然治癒力によって治りやすくなるのだと考えられます。
宮崎)今までの話とは異なる観点なのですが、アルコールでも死なないセレウス菌を殺菌する技術も開発しました。
コロナ禍で多くの人がアルコール消毒をするようになったことをきっかけに、アルコールや加熱処理では殺菌されないセレウス菌が手の平に蔓延し、食中毒の危険性が高まっています。そこで、アルコール消毒液に配合でき、肌に優しい物質でセレウス菌を殺菌する技術を開発しました。
―そもそも、なぜセレウス菌はアルコールで殺菌できないのでしょうか?
宮崎)セレウス菌がアルコールでも殺菌されない原因は、芽胞と呼ばれる植物の種子のような殻を作ってしまうことにあります。この芽胞は乾燥・加熱・紫外線・化学薬品でも死滅することがありません。つまり、この芽胞さえ形成しなければ、セレウス菌はアルコールで死滅することになりますが、アルコール消毒は手を荒らしてしまいます。
そこで、保湿作用の高い肌に優しい物質をアルコール消毒液に配合することで、セレウス菌の芽胞形成を阻害し殺菌する技術を開発しました。
(下図:セレウス菌をシャーレに播種した後、アルコール消毒液をスプレー)。
―今までにない、画期的なアルコール消毒液なんですね。
―最後に、今後の展望について教えてください。
宮崎)まずはメーカーと製品を共同開発してこの技術を世の中に広め、肌トラブルに悩む人がいない世の中を作りたいと考えています。その実現に向け、協業いただける企業を探しています。
―今後の展開がとても楽しみです!
お問い合わせ